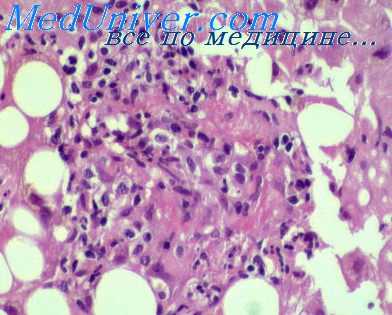
лечение ку-лихорадки

Диагностика риккетсиозов. Лабораторное выявление риккетсиозов
Добавил пользователь Евгений Кузнецов Обновлено: 08.11.2025
ПЦР с детекцией в режиме реального времени. Метод основан на амплификации искомых фрагментов ДНК Rickettsia sibirica/Rickettsia heilongjiangensis с детекцией в режиме реального времени.
Тест предназначен для качественного дифференциального определения ДНК Rickettsia sibirica/Rickettsia heilongjiangensis в гомогенизате клеща.
Краткая характеристика исследования клеща для выявления ДНК возбудителей клещевых риккетсиозов
Кровососущие иксодовые клещи являются переносчиками возбудителей многих заболеваний. Любое заболевание, возникшее в результате укуса клеща, следует рассматривать как потенциальную микст-инфекцию. Ранняя диагностика микст-инфекций важна для выбора правильной стратегии лечения.
Rickettsia sibirica/Rickettsia heilongjiangensis являются возбудителями клещевых риккетсиозов и занимают промежуточное положение между вирусами и бактериями, которые вызывают заболевания, объединённые в группу клещевые пятнистые лихорадки (КПЛ). Rickettsia sibirica является возбудителем сибирского клещевого тифа (СКТ). В научной литературе для СКТ часто используют название «североазиатский клещевой риккетсиоз» (СКР), которое более соответствует современным преставлениям об этом заболевании
R. heilongjiangensis является возбудителем «дальневосточного клещевого риккетсиоза» (ДКР), однако клинические проявления этого заболевания не имеют существенных отличий от СКР, и оно также подлежит официальной регистрации как СКТ.
Клещевой риккетсиоз (КР) наряду с клещевым энцефалитом (КЭ) и иксодовыми клещевыми боррелиозами (ИКБ) входит в тройку наиболее распространенных трансмиссивных инфекций, передаваемых через присасывание иксодовых клещей в России. Клещевой риккетсиоз – облигатно-трансмиссивная природно-очаговая инфекция.
Пути заражения и симптомы риккетсиоза
Заражение людей риккетсиями обусловлено присасыванием клещей – переносчиков риккетсий. Во входных воротах (на месте присасывания) происходит размножение возбудителя в эпителиальных клетках с формированием первичного аффекта. Далее риккетсии распространяются лимфогенно, что может сопровождаться лимфангоитом и регионарным лимфаденитом. Дальнейшее гематогенное распространение возбудителя сопровождается генерализованным поражением эндотелия сосудов, в том числе формированием различной выраженности эндоваскулитов и тромбангиитов в сосочковом слое кожи (сыпь). Патологический процесс при риккетсиозах обусловлен размножением риккетсий в клетках-мишенях (главным образом в эндотелиальных клетках кровеносных сосудов, особенно мелких) и сосудорасширяющим действием токсических субстанций, что вызывает значительные изменения центральной нервной системы и расстройства кровообращения. Имеет место поражение сосудистого аппарата, преимущественно прекапилляров, капилляров и артериол с развитием десквамативно-пролиферативного тромбоваскулита и образованием специфических гранулем в местах паразитирования риккетсий. Этот процесс проявляется постепенным, по мере внутриклеточного размножения риккетсий и гибели инфицированных клеток, развитием инфекционно-токсического синдрома.
Инкубационный период колеблется от 2 до 7 дней, большей частью равен 3-6 дням. В месте присасывания клеща развивается болезненность, гиперемия и небольшой инфильтрат с некротической корочкой в центре, увеличение регионарных лимфатических узлов. Могут отмечаться небольшая слабость, озноб, ломота в суставах, снижение аппетита. Начало заболевания острое, у части больных наблюдают продромальный период, в котором описаны общая слабость и разбитость, боль и ломота в мышцах, костях, суставах, пояснице, небольшое повышение температуры, катаральные изменения в глотке и верхних дыхательных путях. В этом периоде уже выражено специфическое поражение кожи в месте внедрения возбудителя.
На 2-3-й день продромы развивается клиническая картина болезни: повышение температуры тела до 40 ºС, лихорадка, головная боль, бессонница, озноб, ломота и боли во всем теле, могут быть тошнота и рвота. Продолжительность лихорадки 3-18 дней, в среднем 8 дней. На 2-4-й день болезни появляется сыпь. Она является характерным признаком клещевого риккетсиоза и ее раннее появление облегчает клиническую диагностику. Гистология сыпи сходна с сыпнотифозной. Высыпания начинаются с конечностей, характерно наличие сыпи на ладонях и подошвах. Сыпь в течение 1,5-2 суток распространяется на туловище, иногда и на лицо. Имеет вид крупных розеол и папул ярко-розового цвета. Размеры варьируют от мелких элементов величиной с булавочную головку до крупных, размером в 2-3 мм в поперечнике. Иногда сыпь переходит в петехиальную. Типичны локализация сыпи на разгибательных поверхностях и ее обилие на нижних конечностях. Наблюдают медленное угасание сыпи и наличие пигментации на месте ее исчезновения. Наиболее характерны изменения со стороны сердечно-сосудистой системы, выражающиеся в брадикардии и понижении артериального давления. Изменения нервной системы заключаются в резкой головной боли, миалгиях, артралгиях, нарушении сна и аппетита.
Во время лихорадочного периода наблюдается снижение гемоглобина на 15%, уменьшение количества эритроцитов и тромбоцитов.
Особенности течения риккетсиоза у детей
У детей болезнь протекает в более острой форме, но сравнительно легче, чем у взрослых. Особенно тяжело переносят клещевой риккетсиоз пожилые люди. По степени тяжести заболевания различают: тяжелую, среднюю и легкую форму. Тяжелую форму характеризует более длительный лихорадочный период, значительная интоксикация организма, температурные величины, достигающие 41 градуса, более выраженная симптоматика со стороны сердечно-сосудистой и нервной системы, могут быть осложнения в виде неврита, миокардита, бронхита, пиелонефрита и др. Общая клиническая картина клещевого риккетсиоза, из-за многообразия его форм, может различаться и течением болезни, и симптоматикой. Для назначения эффективного лечения очень важна верная диагностика заболевания.
С какой целью проводят исследование клеща для выявления ДНК возбудителей клещевых риккетсиозов
Тест проводится с целью определения наличия в клеще специфических фрагментов ДНК риккетсий (Rickettsia sibirica/Rickettsia heilongjiangensis) – возбудителей риккетсиоза, переносчиком которой являются клещи.
Риккетсиоз
Риккетсиозы – многочисленные инфекционные заболевания, связанные общностью этиологии (возбудители – риккетсии) и эпидемиологии (имеют преимущественно трансмиссивный механизм передачи). Риккетсиозы протекают с возникновением первичного аффекта (при клещевых риккетсиозах), лихорадочным и интоксикационным синдромами, генерализованными васкулитами и кожными высыпаниями. Подтвердить диагноз риккетсиоза и верифицировать его клиническую форму позволяет серологическая диагностика (РИГА, РСК, РНИФ, ИФА). Этиотропная терапия риккетсиозов проводится антибактериальными препаратами из группы тетрациклинов и хлорамфениколом.
Общие сведения
Риккетсиозы – термин, используемый в отношении трансмиссивных лихорадочных заболеваний, вызываемых внутриклеточными возбудителями — риккетсиями. Группа риккетсиозов человека включает в себя сыпной тиф (эндемический и эпидемический), клещевые лихорадки (пятнистую лихорадку Скалистых гор, волынскую лихорадку, марсельскую лихорадку, везикулезный риккетсиоз, североазиатский клещевой риккетсиоз), пароксизмальные риккетсиозы (окопную лихорадку, клещевой пароксизмальный риккетсиоз), лихорадку цуцугамуши и лихорадку Ку. Несмотря на этиологические различия, всем этим заболеваниям свойственны некоторые общие эпидемиологические, патогенетические, патоморфологические, иммунологические и клинические признаки, позволяющие объединить их общим названием – риккетсиозы. Распространенность риккетсиозов повсеместная; наибольшая заболеваемость отмечается в развивающихся странах, где в структуре лихорадок неясной этиологии они составляют 15-25%.
Причины
По своим культуральным качествам риккетсии являются промежуточным звеном между бактериями и вирусами. С микробными возбудителями их сближают морфологические признаки (грамотрицательные палочковидные или кокковидные формы), а с вирусными агентами – способность к внутриклеточному паразитированию. Патогенными для человека являются следующие виды риккетсий (Rickettsia):
- R. Prowazekii – вызывает эпидемический (вшивый) сыпной тиф и его отдаленный рецидив - болезнь Брилла
- R. Typhi – вызывает эндемический (крысиный, блошиный) сыпной тиф
- R. Sibirica – вызывает североазиатский клещевой риккетсиоз
- R. Conorii – вызывает марсельскую лихорадку
- R. Rickettsii – вызывает пятнистую лихорадку Скалистых гор
- R. Australis – вызывает австралийский клещевой риккетсиоз
- R. Quintana (Rochalimea quintana) – вызывает волынскую лихорадку
- R. Akari – вызывает везикулезный риккетсиоз
- R. Japonica — вызывает японскую пятнистую лихорадку
- R. Orientalis – вызывает цуцугамуши
- R. Burneti (Coxiella burnetii) – вызывает Ку-лихорадку
Риккетсиозы делятся на антропонозные, при которых источниками инфекции выступает человек, а переносчиками – вши, и зоонозные, характеризующиеся передачей от животных через укусы клещей. К антропонозам относятся сыпной тиф и окопная лихорадка; к природно-очаговым зоонозам – все остальные риккетсиозы.
Симптомы риккетсиозов
Риккетсиозы группы сыпного тифа
Эпидемический (вшивый) сыпной тиф протекает с лихорадкой, интоксикацией, розеолезно-петехиальной сыпью на коже, поражением сосудистой и нервной системы. Инкубационный период занимает от 5 до 21 дня. Риккетсиоз манифестирует с повышения температуры тела и общеинтоксикационных симптомов, которые достигают максимальной выраженности к 3-6-й день заболевания. В этот период отмечается выраженная гиперемия и одутловатость лица, инъекция склер, энантема на мягком небе. Примерно на 5 сутки на коже боковой поверхности груди, живота, сгибательных поверхностях рук появляется яркая характерная розеолезно-петехиальная сыпь. Через неделю сыпь бледнеет, а на 2-3-й неделе от начала заболевания исчезает. Одновременно снижается температура и исчезает интоксикация, однако еще несколько недель сохраняется постинфекционная астения. При тяжелом течении риккетсиоза возникает поражении ЦНС в виде менингита или энцефалита. Осложнения эпидемического сыпного тифа могут включать отит, паротит, пневмонию, миокардит. Болезнь Бриля, или рецидивирующий сыпной тиф, проявляется теми же симптомами, однако менее выраженными.
Эндемический (крысиный или блошиный) сыпной тиф начинается остро и в начальном периоде характеризуется общеинфекционными симптомами (лихорадкой, познабливанием, артралгиями, головной болью). В разгар лихорадочного периода на груди, животе и на конечностях появляется сыпь, имеющая преимущественно розеолезно-папулезный характер. Характерна артериальная гипотония, брадикардия, общая слабость, головокружение. В целом заболевание протекает легче, чем эпидемический сыпной тиф.
Риккетсиозы группы пятнистых клещевых лихорадок
Североазиатский клещевой риккетсиоз, или клещевой сыпной тиф Северной Азии передается через укусы иксодовых клещей. Типичным признаком клещевого риккетсиоза служит первичный аффект – первичная воспалительная реакция кожи в месте проникновения возбудителя. Он представляет собой болезненное уплотнение, окруженное зоной гиперемии и в центре покрытое коричневым струпом. Одновременно с появлением первичного аффекта повышается температура тела, развивается регионарный лимфаденит и интоксикационный синдром. Кожные высыпания появляются на 2-3-й день и представлены полиморфными розеолезно-папулезными элементами, расположенными на туловище и вокруг суставов. Отмечается гиперемия лица и слизистой зева, брадикардия, гипотония, умеренная гепатоспленомегалия. Течение североазиатского клещевого риккетсиоза доброкачественное; обычно к 14 дню заболевания наступает выздоровление.
Марсельская лихорадка также характеризуется наличием первичного аффекта в месте внедрения клеща, лихорадкой, лимфаденитом, пятнисто-папулезной сыпью. Начальные признаки риккетсиоза аналогичны клещевому сыпному тифу Северной Азии. Первичный аффект выглядит как плотный инфильтрат с центральным некрозом, который в дальнейшем изъязвляется и эпителизируется только в периоде реконвалесценции (через 3-4 недели). На фоне лихорадочно-интоксикационных проявлений выражены гиперемия слизистой ротоглотки, боли в горле, конъюнктивит. Отличительным признаком марсельской лихорадки служит сыпь, которая затрагивает не только тело, но также лицо, ладони и подошвы. Обычно сыпь имеет пятнисто-папулезной характер, но может трансформироваться в прыщи («прыщевидная лихорадка») с геморрагическим содержимым. Угасание сыпи постепенное, на ее месте длительно сохраняется пигментация.
Пятнистая лихорадка Скалистых гор относится к риккетсиозам с тяжелым течением. В остром периоде заболевание сопровождается ознобом, сменяющимся жаром; сильной головной и мышечной болью, носовыми кровотечениями. Неврологические изменения включают бессонницу, нарушение сознания (оглушенность, прострацию), судороги, пара- и гемиплегии, нарушения зрения и слуха. Первичный аффект отсутствует. Сыпь при данном виде риккетсиоза обильная, петехиальная, имеет тенденцию к слиянию с образованием больших пятен. Летальность от этого риккетсиоза достигает 7%.
Пароксизмальные риккетсиозы
Пароксизмальные риккетсиозы протекают с рецидивирующими лихорадочными приступами, повторяющимися каждые 5 дней (при волынской лихорадке) или 2-3 дня (при пароксизмальном клещевом риккетсиозе). Во время приступа температура повышается до 39,0–40,5°С, появляются ознобы, оссалгии, миалгии, артралгии, головные боли. Первичный аффект, кожные высыпания и регионарный лимфаденит не являются постоянными спутниками пароксизмальных риккетсиозов и зачастую отсутствуют. Течение лихорадок обычно затяжное, однако доброкачественное.
Диагностика
Выявление и дифференциальная диагностика риккетсиозов проводится по нескольким направлениям: сбор эпидемиологического анамнеза, анализ клинических данных и лабораторная верификация возбудителя. В эпидемиологическом статусе акцент делается на природно-очаговый характер инфекции, связь заболевания с укусами клещей, педикулезом и т. д. При анализе клинической симптоматики риккетсиозов основное внимание обращается на наличие первичного аффекта, характер и локализацию сыпи.
Лабораторная диагностика риккетсиозов проводится с помощью серологических методов (РСК, РА, РИГА, РИФ, ИФА), позволяющих идентифицировать возбудителя путем определения его антигенов и специфических антител. В ряде случаев возможно выделение риккетсий из крови, мочи, спинномозговой жидкости, биоптатов, биомассы клещей, проведение кожно-аллергических проб. Дифференциальная диагностика риккетсиозов проводится с гриппом, корью, геморрагическими лихорадками, менингококковой инфекцией, брюшным тифом, энтеровирусной инфекцией, аллергией и др.
Лечение риккетсиозов
В качестве средств этиотропной терапии риккетсиоза используются антибиотики тетрациклинового ряда (тетрациклин, доксициклин), хлорамфеникол, фторхинолоны. Обычно курс лечения продолжается весь лихорадочный период и 2-3 дня после нормализации температуры тела. Одновременно проводится дезинтоксикационная, десенсибилизирующая, противовоспалительная терапия. При тяжелом течении риккетсиозов применяются кортикостероидные гормоны.
Прогноз и профилактика
По течению, исходам и процентам летальности к наиболее тяжелым риккетсиозам относятся эпидемический сыпной тиф, пятнистая лихорадка Скалистых гор и цуцугамуши. Остальные риккетсиозы протекают более доброкачественно и редко сопровождаются осложнениями. Профилактика заражения риккетсиозами предусматривает борьбу с педикулезом, клещами и грызунами, соблюдение мер личной защиты от нападения кровососущих насекомых. При укусах клещей рекомендуется проведение экстренной химиопрофилактики доксициклином или азитромицином. С целью профилактики сыпного тифа и лихорадки Ку проводится вакцинация. Больные сыпным тифом подлежат строгой изоляции; за контактировавшими с пациентом лицами устанавливается наблюдение; в очаге инфекции проводится санитарная обработка.
Везикулезный риккетсиоз ( Гамазовый риккетсиоз , Осповидный риккетсиоз , Пятнистая лихорадка Кью-Гардена )
Везикулезный риккетсиоз – это острая трансмиссивная природно-очаговая инфекция. Характерными признаками являются первичный аффект с центральным некрозом и обильная сыпь на теле. Отмечается лихорадка, симптомы общей интоксикации и относительно доброкачественное течение. Основной способ диагностики – выделение генного материала риккетсий (ПЦР), обнаружение антител к возбудителю с помощью серологических методик. Лечебные мероприятия включают этиотропную антибактериальную терапию, применение дезинтоксикационных, жаропонижающих, ангиопротекторных и других средств.
МКБ-10
Везикулезный риккетсиоз (осповидный, гамазовый риккетсиоз, пятнистая лихорадка Кью-Гардена) является зоонозной риккетсиозной болезнью. Первые упоминания об инфекции датируются 1946 годом, когда в Нью-Йорке были зафиксированы случаи везикулезной лихорадки. В последующем аналогичные симптомы описывались в других городах США, Хорватии, Украине, Беларуси, Молдове, Центральной Африке. Ежегодно регистрируются единичные случаи заболевания с сезонным подъемом в мае-сентябре. Среди больных преобладают мужчины преимущественно старше 60 лет, женщины заражаются реже, обычно в возрасте до 45 лет.
Значение везикулезного риккетсиоза для современной инфектологии обусловлено высокой встречаемостью среди потребителей инъекционных наркотиков, бездомных и асоциальных лиц. Данная риккетсиозная патология находится на втором месте после бартонеллезов; в настоящее время увеличивается число случаев некогда казуистической возможности гемоконтактной передачи. Распространенность ВИЧ-инфекции в человеческой популяции способствует возникновению осложненных форм болезни.
Основные факторы риска – внутривенное употребление наркотиков, низкая социальная адаптация, работа в сельском хозяйстве, зернохранилищах, связанная с истреблением грызунов. В группе повышенного риска находятся туристы, военнослужащие, реципиенты донорских органов и препаратов крови, а также население эндемичных районов. В ходе ряда исследований установлено, что экспрессия рецепторов TLR-2 и TLR-4 на клеточных мембранах человека увеличивает риск не только болезни Крона, туберкулеза и ряда других патологий, но и везикулезного риккетсиоза.
Патогенез
Патогенез везикулезного риккетсиоза изучен недостаточно ввиду доброкачественного течения и малого числа летальных исходов. После проникновения в организм человека при укусе переносчика риккетсии формируют специфическую гранулему. Основными клетками, поражаемыми возбудителями, являются макрофаги с рецептором CD-68. Риккетсии способны к выходу из фагосомы и проникновению в цитоплазму макрофагов. Ограничение репликации возбудителей в клетках происходит путем сложных, до конца не изученных реакций с участием интерлейкинов.
Белки-рецепторы TLR-2/4 на поверхности клеток человеческого организма являются активаторами хемокинов и провоспалительных цитокинов, влияющими на опосредованную индукцию экспрессии интерлейкина-8 и ФНО-альфа при распознавании R. akari. Параллельно отмечается умеренная токсинемия, мультиорганное распространение через лимфатическую систему. Эндотелиоциты могут вовлекаться в патологический процесс как место размножения риккетсий, однако чаще всего характерный панваскулит обусловлен токсической реактивацией иммунной системы.
Симптомы везикулезного риккетсиоза
Инкубационный период составляет 7-12 суток, чаще – 10 дней. Заболевание начинается с появления на месте присасывания клеща небольшого безболезненного уплотненного пятна, диаметр которого не превышает 5 см. Кожа вокруг первичного аффекта гиперемирована. Затем в центре формируется бугорок, сменяющийся пузырьком с прозрачным содержимым, потом – язвочка с темной коркой; может образовываться рубец. Примерно в этот период пациент отмечает начало лихорадки с выраженной слабостью, головными болями и головокружением.
Температурная реакция организма достигает 39-40° C, возникают ознобы, мышечно-суставные боли. Лихорадка обычно длится 5-7 суток, может продолжаться до 12 дней. Иногда выявляется болезненное увеличение лимфатических узлов, расстройства стула, боли в животе, сухой кашель. Около 2-4 дня болезни появляется обильная полиморфная сыпь с локализацией на коже головы, туловище, конечностях. Элементы сыпи чрезвычайно разнообразны (бугорки, пятна, пузырьки), вызывают умеренный зуд, сохраняются до 10-х суток заболевания, исчезают бесследно. Органные поражения нехарактерны.
Осложнения
Везикулезный риккетсиоз редко протекает с осложнениями, обычно их появлению предшествует позднее обращение за медицинской помощью либо иммуносупрессивное состояние. Чаще выявляются кожные инфекции, вызванные другими бактериями, поражение лимфатических узлов с формированием гнойных лимфаденитов. Сердечно-сосудистая недостаточность, преходящая патологическая дисфункция центральной нервной системы возникают при выраженной токсинемии. Редкими осложнениями везикулезного риккетсиоза считаются геморрагические инсульты, инфаркты головного мозга.
Верификацию диагноза везикулезного риккетсиоза осуществляет инфекционист. Проводится тщательный сбор эпидемиологического анамнеза на предмет присасывания клеща, пребывания в эндемичных районах. Другие специалисты (чаще всего – дерматовенерологи и терапевты) привлекаются для консультаций при наличии показаний. Основными диагностическими лабораторно-инструментальными признаками заболевания являются:
- Физикальные данные. При объективном исследовании обнаруживается первичный язвенный аффект, покрытый темной коркой; пятнисто-папулезная, везикулезная экзантема на теле, конечностях и волосистой части головы; умеренное увеличение, безболезненность лимфатических узлов, реже – лимфаденит. Перкуторные, аускультативные и пальпаторные признаки висцеральной патологии обычно отсутствуют.
- Лабораторные исследования. Общеклинический анализ крови не имеет специфических маркеров, выявляется лейкопения, нейтропения, тромбоцитопения, увеличение СОЭ. Лейкоцитоз возникает при осложненном течении риккетсиоза. В биохимическом анализе отмечается транзиторное увеличение активности АЛТ, АСТ. В общем анализе мочи на фоне лихорадки могут определяться следы белка, эритроцитурия.
- Выявление инфекционных агентов. Изоляция риккетсий в культуре клеток – трудоемкий, длительный и дорогостоящий процесс. Наиболее информативным методом обнаружения возбудителей служит мультиплексная ПЦР, проводимая с мазками-отпечатками первичного аффекта, биоптатами кожи. Серологические реакции (ИФА) необходимо повторять с интервалами не менее 10-14 дней для фиксации роста титра антител.
- Инструментальные методики. С целью дифференциального диагноза пациентам выполняется рентгенография ОГК. По показаниям рекомендуется ультразвуковое исследование брюшной полости, почек, мягких тканей, лимфатических узлов. Для исключения токсического поражения миокарда назначается ЭКГ, при неврологических нарушениях целесообразна МРТ, КТ с контрастированием.
Дифференциальный диагноз проводится с сыпным тифом, характеризующимся тяжелым течением, наличием розеолезно-петехиальной сыпи и неврологическими поражениями; ветряной оспой с истинным полиморфизмом высыпаний, энантемой и феноменом подсыпания; инфекционным мононуклеозом, для которого типичны выраженная лимфаденопатия, тонзиллит и гепатоспленомегалия. Отличиями менингококковой инфекции считаются истинная геморрагическая сыпь, начинающаяся с нижних конечностей, выраженная интоксикация, симптомы вовлечения ЦНС.
Признаками кори являются высыпания, начинающиеся с лица и верхней половины тела, конъюнктивит, поражения слизистых; иксодовый клещевой боррелиоз протекает с мигрирующей эритемой, поражением печени, опорно-двигательного аппарата. Системная красная волчанка отличается эритематозным фотодерматитом, телеангиоэктазиями, синдромом Шегрена, симметричным поражением крупных суставов. Тромбоцитопеническая пурпура возникает без повышения температуры тела, типичные проявления – спонтанные полиморфные кровоизлияния в кожу и слизистые, кровотечения.
Лечение везикулезного риккетсиоза
Пациенты с подозрением на данную патологию подлежат госпитализации только в случае тяжелого течения либо при необходимости дифференциальной диагностики. Постельный режим назначается до нормализации температуры тела и в течение 2-3 суток стойкого безлихорадочного периода. Специальная диета не разработана, рекомендуется отказаться от приема потенциальных пищевых аллергенов, никотина и алкоголя, в связи с возможными побочными эффектами применяемых антибиотиков – от трудноперевариваемой еды. Водная нагрузка увеличивается при отсутствии противопоказаний.
Консервативная терапия
Препаратами выбора для лечения везикулезного риккетсиоза являются антибиотики. Наибольшая чувствительность возбудителя отмечена к доксициклину, хлорамфениколу, тетрациклину, макролидам. Применение пенициллинов, ванкомицина, аминогликозидов требует высокодозовых введений. Обязательно назначают ангиопротекторы и противовоспалительные средства, проводят пероральную и внутривенную дезинтоксикацию. Применять аспирин и аналоги следует с осторожностью. Симптоматическое лечение подбирается с учетом клинической необходимости у конкретного пациента.
Прогноз благоприятный, характерно самоограничение болезни со спонтанным выздоровлением. В случае осложненного течения, тяжелых преморбидных состояний летальность достигает 2,8%. Продолжительность везикулезного риккетсиоза обычно не превышает 7-10 дней. Специфическая профилактика (вакцина) не разработана. К неспецифическим мерам защиты относятся плановая дератизация, применение акарицидной обработки, противоклещевых спреев, одежды с длинными рукавами и штанинами, перчаток при нахождении в природно-очаговых зонах обитания гамазовых клещей.
3. Involvement of TLR2 and TLR4 in cell responses to Rickettsia akari/ Marco A. Quevedo-Diaz, Chang Song,Yanbao Xiong// J Leukoc Biol. - 2010 - №4.
Диагностика риккетсиозов. Лабораторное выявление риккетсиозов
Диагностика и лечение Ку-лихорадки. Профилактика Ку-риккетсиоза
При лихорадке Ку эффективны тетрациклины и левомицетин в обычных терапевтических дозах, применяемые в течение 5-7 дней (по 0,5 г 4 раза в день). Если температура при этом лечении не снижается, то через 3 дня их применения переходят на другие антибиотики (рифампицин). Возможны комбинация тетрациклина с бактримом. При тяжелых формах антибиотики вводят внутривенно. Рекомендуется сочетать этиотропную терапию с антигистаминными и противовоспалительными препаратами (бутадион, амидопирин). При отсутствии эффекта назначают глюкокортикоидные гормоны, в частности, преднизолон по 30-60 мг в сутки, дексаметазон (по 4-8 мг), триамсиналон (по 20 мг в сутки) или гидрокортизон (по 80-120 мг в сутки). Длительность гормональной терапии 5-8 дней. Проводят также дезинтоксикационную и симптоматическую терапию.
Профилактика Ку-риккетсиоза
Лихорадка Ку распространена во многих странах мира. По официальным данным, в России в разные годы регистрируется до 1,5-2 тыс. случаев заболеваний. Северные области России почти свободны от лихорадки Ку. При этом следует учесть возможность легких и стертых форм, которые не диагностируются. Человек как источник инфекции в распространении лихорадки Ку роли не играет.
Резервуаром и источником инфекции в природе являются более 90 видов мелких млекопитающих (преимущественно грызунов), около 60 видов птиц и 70 видов клещей (у клещей сохранение вируса длительное, так как возможна трансовариальная передача риккетсий). Возбудитель, кроме трансмиссивной передачи, попадает в организм человека аэрогенно (чаще всего с пылью, в которой содержатся экскременты больных животных). В антропургических очагах источником инфекции являются сельскохозяйственные домашние животные (крупный и мелкий рогатый скот), которые инфицируются от природных источников инфекции. Заражение человека происходит контактным (раздавливание клещей перед доением коров), алиментарным и трансмиссивным путями. Преобладают аэрогенный и пищевой путь заражения (через молоко и молочные продукты).
Зооветеринарные работники могут заражаться в период наступления у животных отелов, окотов, когда им приходится оказывать помощь. Околоплодные воды животных содержат практически чистую культуру риккетсий, так же как при бруцеллезе. Болеют лихорадкой Ку люди всех возрастов и обоих полов. Наибольшему риску заражения подвержены лица, связанные своей трудовой деятельностью с уходам за животными и обработкой продуктов животноводства. Заболевания возникают в любое время года, но чаще в период отелов и окотов; эпидемические вспышки лихорадки Ку связаны с завозом сельскохозяйственной продукции (шерсть, хлопок, солома и др.) из местности, неблагополучной по этому заболеванию.
Профилактика основана на социально-гигиенических и ветеринарных предупредительных мерах. Вакцинацию против лихорадки Ку проводят по эпидемическим показаниям лицам угрожаемых профессий.
- Вернуться в оглавление раздела "Микробиология."
Информация на сайте подлежит консультации лечащим врачом и не заменяет очной консультации с ним.
См. подробнее в пользовательском соглашении.
Риккетсии по своим морфологическим и биологическим свойствам занимают промежуточное положение между бактериями (видны в обычный микроскоп при специальных методах окраски) и вирусами (они также не способны, за редким исключением, к размножению вне клеток хозяина). Лабораторная диагностика сводится к тем же методам индикации их в биологических жидкостях и в тканях органов, поражаемых при риккетсиозах, как и при вирусных инфекциях.
Кроме метода Романовского, используют методы импрегнации серебром по М.А. Морозову, окраску по Маккиавелло в модификации П.Ф. Здродовского и др.

Для серологической диагностики риккетсиозов применяют те же методы, что для диагностики бактериальных и вирусных инфекций с некоторой их модификацией. В клинической практике применяют реакцию агглютинации, РСК, РГА. Кроме того, для специальных исследований используют реакцию нейтрализации токсического действия риккетсии, реакцию опсонизации и др. В лабораторной диагностике риккетсиозов важное место занимают люминесцентная микроскопия и люминисцентно-серологичский метод, а также электронная микроскопия.
По аналогии с бруцеллезом и туляремией с определенным успехом стали применять аллергодиагностику лихорадки Ку, используемую при широких эпидемиологических обследованиях животных для выявления среди них источников инфекций. В клинической практике внутрикожная проба с аллергеном риккетсии Бернетта для диагностики лихорадки Ку имеет ограниченное применение. С ее помощью установлено, что специфическая аллергия выявляется на 1-й неделе болезни и сохраняется у переболевших до 4 лет. Другой важной особенностью лихорадки Ку является позднее образование у больных специфических антител.
У некоторых они появляются только к 4-6-й неделе от начала болезни. Применяемая в этих случаях РСК имеет ретроспективное диагностическое значение, но ее выполнение необходимо для точной верификации диагноза лихорадки Ку.
В научно-исследовательской работе выделение чистых культур риккетсий осуществляется с помощью тех же методов, что и при выделении вирусов, с той лишь разницей, что при риккетсиозах есть свои дополнительные методы, например, получение штаммов риккетсий на вшах (выделение возбудителя сыпного тифа). Идентификацию выделенных штаммов риккетсий проводят морфологическим методом и в эксперименте на животных. Экспериментальной моделью воспроизведения риккетсиозной инфекции служат морские свинки - самцы.
При внутрибрюшном заражении развивается скротальный феномен (опухоль и отек яичек), откуда можно получить материал, содержащий риккетсий. При заражении морских свинок R. prowazeki, R. moosen, D Siberians, D. murinus инфекция протекает доброкачественно. Смертельный исход у морских свинок наблюдается при заражении R tsutsugamushi, R.burnetti; при других возбудителях погибают и белые мыши.
Читайте также:
- Диагностика радикулярных кист. Рентгеновская диагностика кист зубов
- Печень при болезни Рандю-Вебера-Ослера - диагностика
- Поперечная перегородка эмбриона. Плевральная полость плода
- Смертельные исходы при туберкулезе. Предоперационная подготовка в фтизиохирургии
- Синдром недостаточности тазовых органов. Синдром обструкции или анизма
